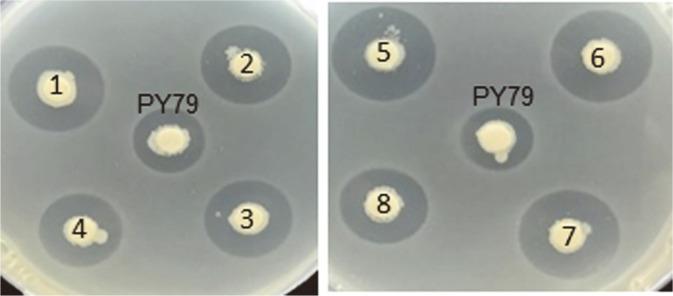
https://cdn.ncbi.nlm.nih.gov/pmc/blobs/c179/10084748/a5f6d89ff8f6/jmb-33-3-410-f3.jpg

通过 CRISPR/Cas9 介导的 操纵子 5'-非翻译区编辑提高 中 Bacilysin 的产量。
Improvement of Bacilysin Production in by CRISPR/Cas9-Mediated Editing of the 5'-Untranslated Region of the Operon.
机构信息
Dr. Orhan Ocalgiray Molecular Biology, Biotechnology and Genetics Research Center (ITU-MOBGAM), Istanbul Technical University, Maslak, Istanbul 34469, Turkey.
Biotechnology Department, Collage of Science, University of Baghdad, Baghdad, Iraq.
出版信息
J Microbiol Biotechnol. 2023 Mar 28;33(3):410-418. doi: 10.4014/jmb.2209.09035. Epub 2022 Dec 13.
Bacilysin is a dipeptide antibiotic composed of L-alanine and L-anticapsin produced by certain strains of . Bacilysin is gaining increasing attention in industrial agriculture and pharmaceutical industries due to its potent antagonistic effects on various bacterial, fungal, and algal pathogens. However, its use in industrial applications is hindered by its low production in the native producer. The biosynthesis of bacilysin is mainly based on the operon. Examination of the sequence surrounding the upstream of the operon did not reveal a clear, strong ribosome binding site (RBS). Therefore, in this study, we aimed to investigate the impact of RBS as a potential route to improve bacilysin production. For this, the 5' untranslated region (5'UTR) of the operon was edited using the CRISPR/Cas9 approach by introducing a strong ribosome binding sequence carrying the canonical Shine-Dalgarno sequence (TAAGGAGG) with an 8 nt spacing from the AUG start codon. Strong RBS substitution resulted in a 2.87-fold increase in bacilysin production without affecting growth. Strong RBS substitution also improved the mRNA stability of the operon. All these data revealed that extensive RBS engineering is a promising key option for enhancing bacilysin production in its native producers.
杆菌肽是一种由某些 产生的二肽抗生素,由 L-丙氨酸和 L-反式缬氨酸组成。由于其对各种细菌、真菌和藻类病原体具有强大的拮抗作用,杆菌肽在工业农业和制药行业中受到越来越多的关注。然而,由于其在天然产生菌中的产量低,其在工业应用中受到阻碍。杆菌肽的生物合成主要基于 操纵子。对 操纵子上游序列的检查并未显示出清晰、强大的核糖体结合位点 (RBS)。因此,在本研究中,我们旨在研究 RBS 作为提高杆菌肽产量的潜在途径的影响。为此,我们使用 CRISPR/Cas9 方法编辑了 操纵子的 5'非翻译区 (5'UTR),通过引入携带经典 Shine-Dalgarno 序列 (TAAGGAGG)的强核糖体结合序列,该序列与 AUG 起始密码子有 8 个核苷酸的间隔。强 RBS 取代导致杆菌肽产量增加了 2.87 倍,而不影响生长。强 RBS 取代还提高了 操纵子的 mRNA 稳定性。所有这些数据表明,广泛的 RBS 工程是增强其天然产生菌中杆菌肽产量的有前途的关键选择。